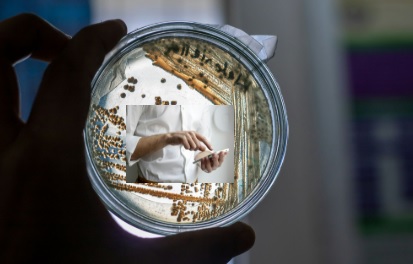
A Petri dish containing bacterial growth. An individual's hand is visible in the centre scrolling on a phone.

The role of Mobile Phones as Vectors of Infectious Disease is particularly relevant in households with young children. While concerns often focus on radiation exposure, blue light, and screen addiction, an equally important issue is microbial transfer.
Image: Photo by Araf Ibne Alam on Unsplash and Photo by NordWood Themes on Unsplash
Mobile Phones as Vectors of Infectious Disease are increasingly recognised as a public health concern, particularly as their use extends into high-risk environments such as bathrooms. These devices function as fomites—objects capable of carrying and transmitting bacteria, viruses, and fungi.
Common examples include doorknobs, clothing, medical equipment, and frequently used electronic devices such as mobile phones, tablets, laptops, and pens, all of which are handled regularly and often inadequately disinfected.
Pathogens such as norovirus can survive for prolonged periods on surfaces, enabling indirect transmission between environments and individuals.
Microbial Contamination
A 2025 study by Olsen et al. identified over 2,200 microbial species on mobile phones, including bacteria, viruses, fungi, and protozoa. Clinically significant organisms such as ESKAPE (antibiotic-resistant pathogens) and HACEK (associated with infective endocarditis and other infections) were detected.
The presence of antimicrobial resistance genes and virulence factors highlights the potential for mobile devices to act as reservoirs of clinically relevant microbes.
Hygiene and Transmission
Mobile devices are handled continuously yet infrequently disinfected, allowing microbes to transfer between hands, surfaces, and the face. This creates a cycle of contamination through repeated handling and contact.
These risks are further amplified by behavioural patterns, particularly smartphone use in high-contamination environments.
Behavioural Risk: Toilet Use
Smartphone use on the toilet is increasingly common and associated with prolonged sitting time. Research suggests this behaviour may increase the risk of hemorrhoids due to sustained pressure, while also increasing exposure to contaminated surfaces and aerosolised particles.
Children and Vulnerable Groups

Photo by Jill Sauve on Unsplash
The role of mobile phones as vectors of infectious disease is particularly relevant in households with young children. While concerns often focus on radiation exposure, blue light, and screen addiction, an equally important issue is microbial transfer.
Caregivers should be aware that mobile phones can harbour and transfer bacteria even after handwashing. This creates a cycle of recontamination, where clean hands come into contact with contaminated devices, potentially increasing exposure risks for children whose immune systems are still developing.
Limitations and Public Health Implications
Current evidence demonstrates contamination but does not establish direct causation of disease. Further research is required to quantify risk and inform policy. Development of hygiene guidelines—particularly in healthcare and public settings—may be warranted.
Practical Advice
Regular cleaning of mobile devices using appropriate disinfectants, limiting use in high-risk environments, and increasing awareness are practical steps to reduce risk.
Conclusion
Mobile Phones as Vectors of Infectious Disease represent an under-recognised pathway for microbial transmission. Improved hygiene practices and behavioural awareness are essential to mitigate potential public health risks.
These findings demonstrate that mobile phones can act as mobile reservoirs of microbial life, effectively functioning as “petri dishes” that facilitate indirect spread and transmission across geographical boundaries.
Your phone is covered in germs: a tech expert explains how to clean it without doing damage
References
Further reading: Study explores a concerning link between digital screen time and breast cancer risk https://www.emfsa.co.za/research-and-studies/study-explores-a-concerning-link-between-digital-screen-time-and-breast-cancer-risk/
